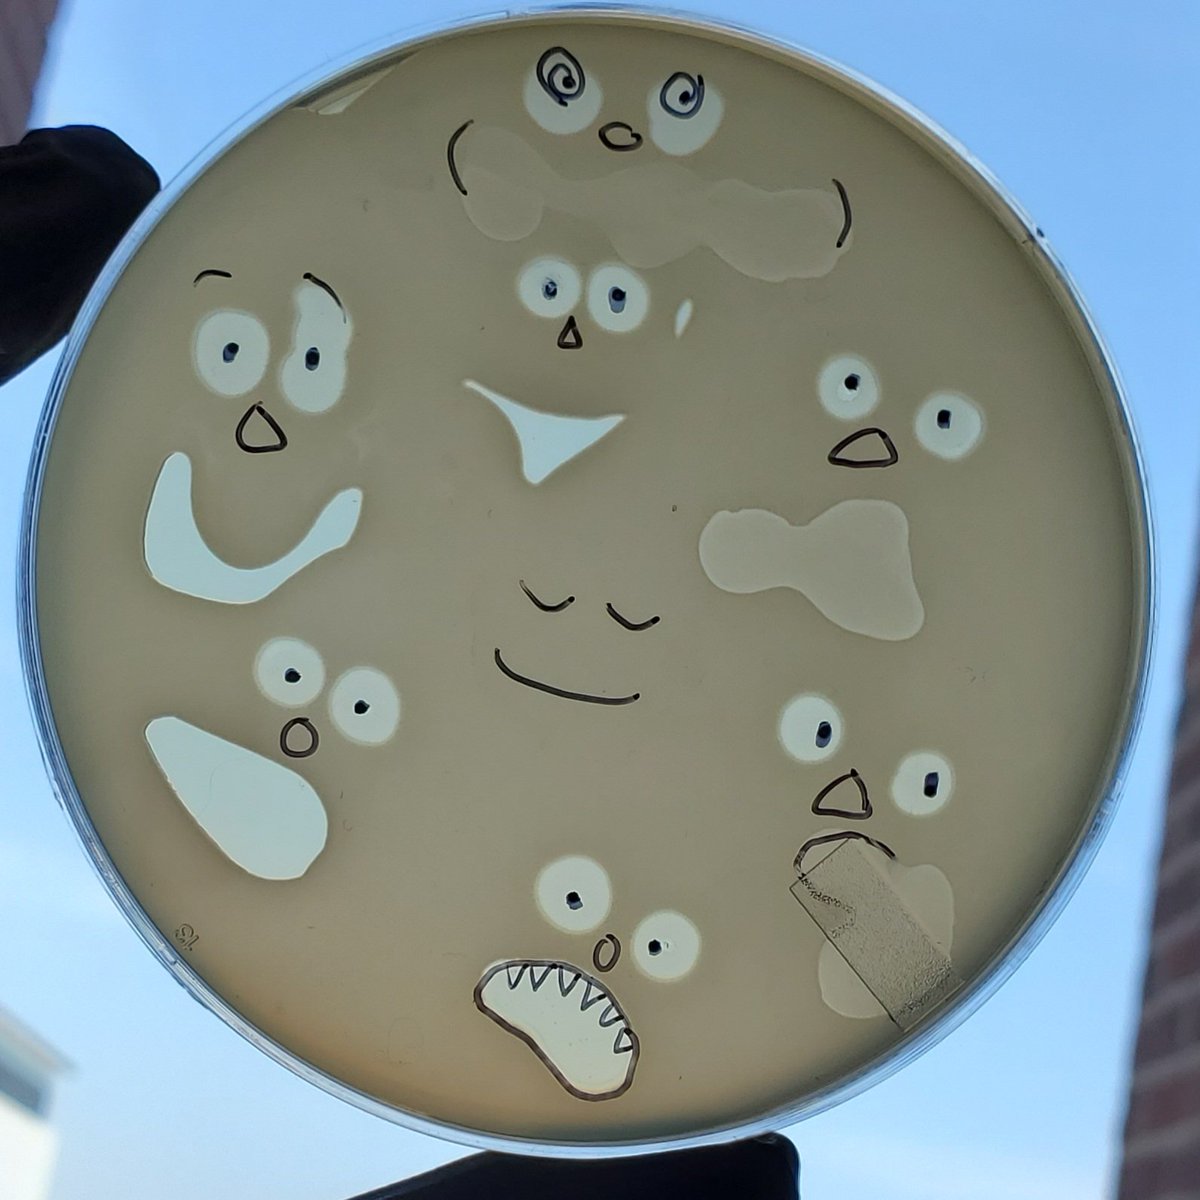
Klebsi_Ella_R's tweet image. Little plate of horrors.

Spëkter Wolffie 🐺🦠🔬
@microbewolf
Grey wolf with a BSc in Microbiology (Penn State University) 🐾. Microbiology PhD student at NC State University. Opinions my own. Banner by @naluthecatfish
You might like
I finally have an updated official reference sheet of my fursona! Thank you so so much @NaluCatfish for bringing my boy to life! Spëkter represents me and my personality, and I am so glad to have an official reference of him now. Thank you again!!!!

alive.

There is a major lack of microbial/music parody stickers. Thankfully I'm here to change that! pinkpetri.etsy.com

Little plate of horrors.
Received news that my role will no longer exist after restructuring and, as a result, I was laid off effective today. If anyone is looking for an incredibly passionate zoologist, science communicator, community manager, or social media manager - my DMs are open.
Thrilled to share 2 chapters of my PhD work on methylotrophic #archaea in hot springs, out now @Nature! We cultivated two different classes of methanogens from the phylum Thermoproteota: Methanomethylicia (rdcu.be/dOPyF) and Korarchaeia (rdcu.be/dOPyp).
Wait, so with this new update, does this mean that only I can see the things I have "liked?" In other words, the "likes" tab is only visible to me?
Seeing double?! Too many border collies to handle @merlebark
10K raffle? It's close, I can feel it. Follow and RT for a chance to win a fox's eternal gratitude. 🧡

The Winogradsky column's Great Black Spot continues to grow.

An old (~2010) Winogradsky column sitting in my office window has started to develop a great black spot 🤔 #winogradsky #winogradskycolumn #greatblackspot

In 1985, I asked my brother David (age 15) to be the rotoscope model for my new game, Prince of Persia. 38 years later, I've made him a (present day) cartoon character in my new graphic novel memoir REPLAY. jordanmechner.com/en/books/repla… Thanks, bro! @01FirstSecond @stripepress…
hey sorry i didn't respond i started cooking a recipe that said it would take 30 minutes and it actually took 40 years
I made dis, and I have never animated before, so I want your feedback!!!! I wanna make this into a ych, so what should I do differently?
I'VE BEEN TO HELL BEFORE DROPPED TODAY! FIND THE LINK TO IT IN MY BIO! #fursuitfriday #furry #poppunkwolf #furryfandom #fursuit #fursuiter #bassit #musician #newmusic #newalbum #poppunk #poppunksnotdead #livemusic
It's almost album time! "I've Been To Hell Before..." Release on April 26th to ALL STREAMING PLATFORMS!

Hi guys👋! When a simple visit turns into a lifelong friendship🤗😌. Greetings!




United States Trends
- 1. Hobbs N/A
- 2. #AEWDynamite N/A
- 3. Verizon N/A
- 4. Hubert N/A
- 5. Stanford N/A
- 6. #NYGiants N/A
- 7. Precious Achiuwa N/A
- 8. Boopie Miller N/A
- 9. Ebuka Okorie N/A
- 10. Isaiah Evans N/A
- 11. Bandido N/A
- 12. Caleb Martin N/A
- 13. Caleb Wilson N/A
- 14. #SistasOnBET N/A
- 15. Koa Peat N/A
- 16. #ChicagoPD N/A
- 17. Yanic N/A
- 18. North Minneapolis N/A
- 19. Brice Sensabaugh N/A
- 20. Sean Miller N/A
You might like
-
 Mariana Byndloss
Mariana Byndloss
@Mari_Byndloss -
 Jennie
Jennie
@fairydropart -
 ☢️Nuke Creations☢️
☢️Nuke Creations☢️
@nukecreations -
 Miko/Wade🌺
Miko/Wade🌺
@StuffyMiko -
 Prof Alison Van Eenennaam (@BioBeef)
Prof Alison Van Eenennaam (@BioBeef)
@BioBeef -
 John Wallaby
John Wallaby
@johnwallaby -
 The Folklore Centre, Todmorden
The Folklore Centre, Todmorden
@CentreMyth -
 Zbiggi
Zbiggi
@wojtysiak22 -
 Faolan 🇨🇦
Faolan 🇨🇦
@BrujoFaolan -
 ✨Alder✨
✨Alder✨
@aldermoth -
 Opal! 💛🤍💜🖤
Opal! 💛🤍💜🖤
@OpalCompass -
 Nova Longtail 🏳️⚧️🦈
Nova Longtail 🏳️⚧️🦈
@BlondeHairFoxy -
 Rakuen Growlithe
Rakuen Growlithe
@RakuenGrowlithe
Something went wrong.
Something went wrong.














































































































































